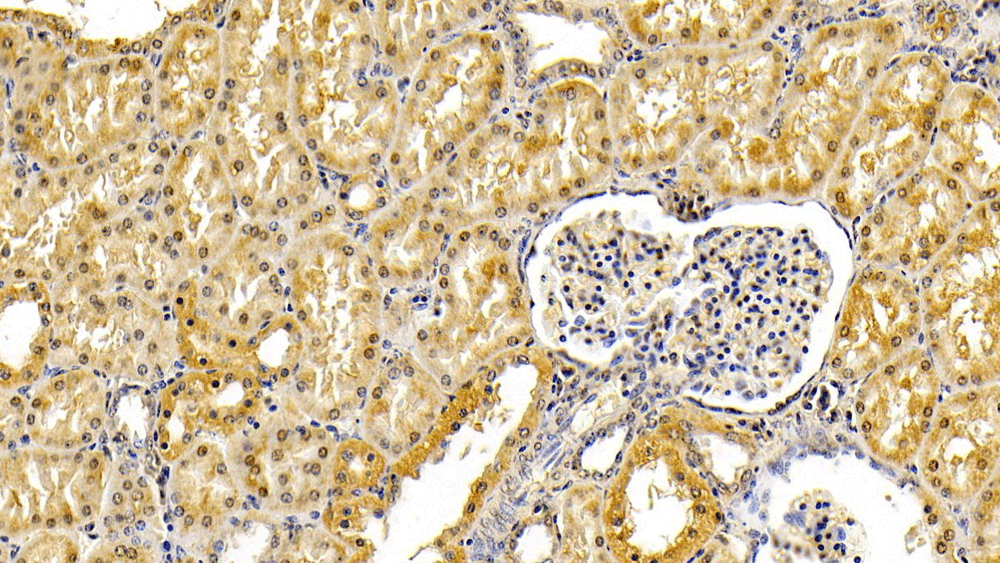
product-image-AAA141790_IHC8.jpg

Mouse V-Ha-Ras Harvey Rat Sarcoma Viral Oncogene Homolog ELISA Kit | HRAS elisa kit
Mouse V-Ha-Ras Harvey Rat Sarcoma Viral Oncogene Homolog ELISA Kit
Gene Names
HRAS; CTLO; HAMSV; HRAS1; RASH1; p21ras; C-H-RAS; H-RASIDX; C-BAS/HAS; C-HA-RAS1
Reactivity
Mouse
Synonyms
V-Ha-Ras Harvey Rat Sarcoma Viral Oncogene Homolog; N/A; Mouse V-Ha-Ras Harvey Rat Sarcoma Viral Oncogene Homolog ELISA Kit; HRAS elisa kit
Reactivity
Mouse
Assay Type
Sandwich
Preparation and Storage
Store all reagents at 2-8 degree C.
Related Product Information for HRAS elisa kit
Intended Uses: This HRAS ELISA kit is intended Laboratory for research use only.The Stop Solution changes the color from blue to yellow and the intensity of the color is measured at 450 nm using a spectrophotometer. In order to measure the concentration ofHRAS in the sample, thisHRAS ELISA Kit includes a set of calibration standards. The calibration standards are assayed at the same time as the samples and allow the operator to produce a standard curve of Optical Density versusHRAS concentration. The concentration ofHRAS in the samples is then determined by comparing the O.D. of the samples to the standard curve
Principle of the Assay: This HRAS enzyme linked immunosorbent assay applies a technique called a quantitative sandwich immunoassay. The microtiter plate provided in this kit has been pre-coated with a monoclonal antibody specific forHRAS. Standards or samples are then added to the microtiter plate wells andHRAS if present, will bind to the antibody pre-coated wells. In order to quantitatively determine the amount ofHRAS present in the sample, a standardized preparation of horseradish peroxidase (HRP)-conjugated polyclonal antibody, specific forHRAS are added to each well to "sandwich" theHRAS immobilized on the plate. The microtiter plate undergoes incubation, and then the wells are thoroughly washed to remove all unbound components. Next, A and B substrate solution is added to each well. The enzyme (HRP) and substrate are allowed to react over a short incubation period.Only those wells that containHRAS and enzyme-conjugated antibody will exhibit a change in colour. The enzyme-substrate reaction is terminated by the addition of a sulphuric acid solution and the colour change is measured spectrophotometrically at a wavelength of 450 nm.
Principle of the Assay: This HRAS enzyme linked immunosorbent assay applies a technique called a quantitative sandwich immunoassay. The microtiter plate provided in this kit has been pre-coated with a monoclonal antibody specific forHRAS. Standards or samples are then added to the microtiter plate wells andHRAS if present, will bind to the antibody pre-coated wells. In order to quantitatively determine the amount ofHRAS present in the sample, a standardized preparation of horseradish peroxidase (HRP)-conjugated polyclonal antibody, specific forHRAS are added to each well to "sandwich" theHRAS immobilized on the plate. The microtiter plate undergoes incubation, and then the wells are thoroughly washed to remove all unbound components. Next, A and B substrate solution is added to each well. The enzyme (HRP) and substrate are allowed to react over a short incubation period.Only those wells that containHRAS and enzyme-conjugated antibody will exhibit a change in colour. The enzyme-substrate reaction is terminated by the addition of a sulphuric acid solution and the colour change is measured spectrophotometrically at a wavelength of 450 nm.
Product Categories/Family for HRAS elisa kit
NCBI and Uniprot Product Information
NCBI GI #
NCBI GeneID
Molecular Weight
18,870 Da
NCBI Official Full Name
HRAS, partial
NCBI Official Synonym Full Names
Harvey rat sarcoma viral oncogene homolog
NCBI Official Symbol
HRAS
NCBI Official Synonym Symbols
CTLO; HAMSV; HRAS1; RASH1; p21ras; C-H-RAS; H-RASIDX; C-BAS/HAS; C-HA-RAS1
NCBI Protein Information
GTPase HRas; p19 H-RasIDX protein; c-has/bas p21 protein; transforming protein p21; Ha-Ras1 proto-oncoprotein; c-ras-Ki-2 activated oncogene; GTP- and GDP-binding peptide B; transformation gene: oncogene HAMSV; Harvey rat sarcoma viral oncoprotein; Ras family small GTP binding protein H-Ras; v-Ha-ras Harvey rat sarcoma viral oncogene homolog
UniProt Protein Name
GTPase HRas
UniProt Gene Name
HRAS
UniProt Synonym Gene Names
HRAS1
UniProt Entry Name
RASH_HUMAN
Customer Reviews
Loading reviews...
Share Your Experience
Similar Products
Product Notes
The Mouse HRAS hras (Catalog #AAA86432) is an ELISA Kit and is intended for research purposes only. The product is available for immediate purchase. The AAA86432 ELISA Kit recognizes Mouse HRAS. It is sometimes possible for the material contained within the vial of "V-Ha-Ras Harvey Rat Sarcoma Viral Oncogene Homolog, ELISA Kit" to become dispersed throughout the inside of the vial, particularly around the seal of said vial, during shipment and storage. We always suggest centrifuging these vials to consolidate all of the liquid away from the lid and to the bottom of the vial prior to opening. Please be advised that certain products may require dry ice for shipping and that, if this is the case, an additional dry ice fee may also be required.Precautions
All products in the AAA Biotech catalog are strictly for research-use only, and are absolutely not suitable for use in any sort of medical, therapeutic, prophylactic, in-vivo, or diagnostic capacity. By purchasing a product from AAA Biotech, you are explicitly certifying that said products will be properly tested and used in line with industry standard. AAA Biotech and its authorized distribution partners reserve the right to refuse to fulfill any order if we have any indication that a purchaser may be intending to use a product outside of our accepted criteria.Disclaimer
Though we do strive to guarantee the information represented in this datasheet, AAA Biotech cannot be held responsible for any oversights or imprecisions. AAA Biotech reserves the right to adjust any aspect of this datasheet at any time and without notice. It is the responsibility of the customer to inform AAA Biotech of any product performance issues observed or experienced within 30 days of receipt of said product. To see additional details on this or any of our other policies, please see our Terms & Conditions page.Item has been added to Shopping Cart
If you are ready to order, navigate to Shopping Cart and get ready to checkout.